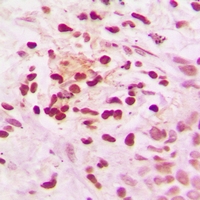

ARG65813
anti-NCOR1 antibody
anti-NCOR1 antibody for ICC/IF,IHC-Formalin-fixed paraffin-embedded sections,Western blot and Human
概述
| 产品描述 | Rabbit Polyclonal antibody recognizes NCOR1 |
|---|---|
| 反应物种 | Hu |
| 应用 | ICC/IF, IHC-P, WB |
| 宿主 | Rabbit |
| 克隆 | Polyclonal |
| 同位型 | IgG |
| 靶点名称 | NCOR1 |
| 抗原物种 | Human |
| 抗原 | KLH-conjugated synthetic peptide around the N-terminus of Human NCOR1. |
| 偶联标记 | Un-conjugated |
| 別名 | N-CoR1; N-CoR; Nuclear receptor corepressor 1; TRAC1; PPP1R109; hN-CoR |
应用说明
| 应用建议 |
|
||||||||
|---|---|---|---|---|---|---|---|---|---|
| 应用说明 | IHC-P: Antigen Retrieval: Sodium citrate buffer (10mM, pH 6.0), Boiling bathing for 20 min. * The dilutions indicate recommended starting dilutions and the optimal dilutions or concentrations should be determined by the scientist. |
属性
| 形式 | Liquid |
|---|---|
| 纯化 | Affinity purification with immunogen. |
| 缓冲液 | Liquid (pH 7.3), 0.42% Potassium phosphate, 0.87% NaCl, 0.01% Sodium azide and 30% Glycerol. |
| 抗菌剂 | 0.01% Sodium azide |
| 稳定剂 | 30% Glycerol |
| 存放说明 | For continuous use, store undiluted antibody at 2-8°C for up to a week. For long-term storage, aliquot and store at -20°C. Storage in frost free freezers is not recommended. Avoid repeated freeze/thaw cycles. Suggest spin the vial prior to opening. The antibody solution should be gently mixed before use. |
| 注意事项 | For laboratory research only, not for drug, diagnostic or other use. |
生物信息
| 数据库连接 | |
|---|---|
| 基因名称 | NCOR1 |
| 全名 | nuclear receptor corepressor 1 |
| 背景介绍 | This gene encodes a protein that mediates ligand-independent transcription repression of thyroid-hormone and retinoic-acid receptors by promoting chromatin condensation and preventing access of the transcription machinery. It is part of a complex which also includes histone deacetylases and transcriptional regulators similar to the yeast protein Sin3p. This gene is located between the Charcot-Marie-Tooth and Smith-Magenis syndrome critical regions on chromosome 17. Alternate splicing results in multiple transcript variants. Pseudogenes of this gene are found on chromosomes 17 and 20.[provided by RefSeq, Jun 2010] |
| 生物功能 | Mediates transcriptional repression by certain nuclear receptors. Part of a complex which promotes histone deacetylation and the formation of repressive chromatin structures which may impede the access of basal transcription factors. Participates in the transcriptional repressor activity produced by BCL6. [UniProt] |
| 预测分子量 | 270 kDa |
| 翻译后修饰 | Ubiquitinated; mediated by SIAH2 and leading to its subsequent proteasomal degradation. |
检测图片 (3) Click the Picture to Zoom In
-
ARG65813 anti-NCOR1 antibody ICC/IF image
Immunocytochemistry: Formalin-fixed HeLa cells were permeabilized with 0.1% Triton X-100 in TBS for 5-10 min and blocked with 3% BSA-PBS for 30 min at RT. Cells were stained with ARG65813 anti-NCOR1 antibody in 3% BSA-PBS and incubated overnight at 4°C in a humidified chamber. Cells were washed with PBST and incubated with a DyLight 594-conjugated secondary antibody (red) in PBS at RT in the dark. DAPI was used to stain the cell nuclei (blue).
-
ARG65813 anti-NCOR1 antibody IHC-P image
Immunohistochemistry: Formalin-fixed and paraffin-embedded Human breast cancer tissue section. Antigen retrieval: Sodium citrate buffer (10mM, pH 6.0), Boiling bathing for 20 min. The section was stained with ARG65813 anti-NCOR1 antibody at RT and detected using an HRP conjugated compact polymer system. DAB was used as the chromogen. The section was then counterstained with haematoxylin and mounted with DPX.
-
ARG65813 anti-NCOR1 antibody WB image
Western blot: K562 and HeLa whole cell lysates stained with ARG65813 anti-NCOR1 antibody.